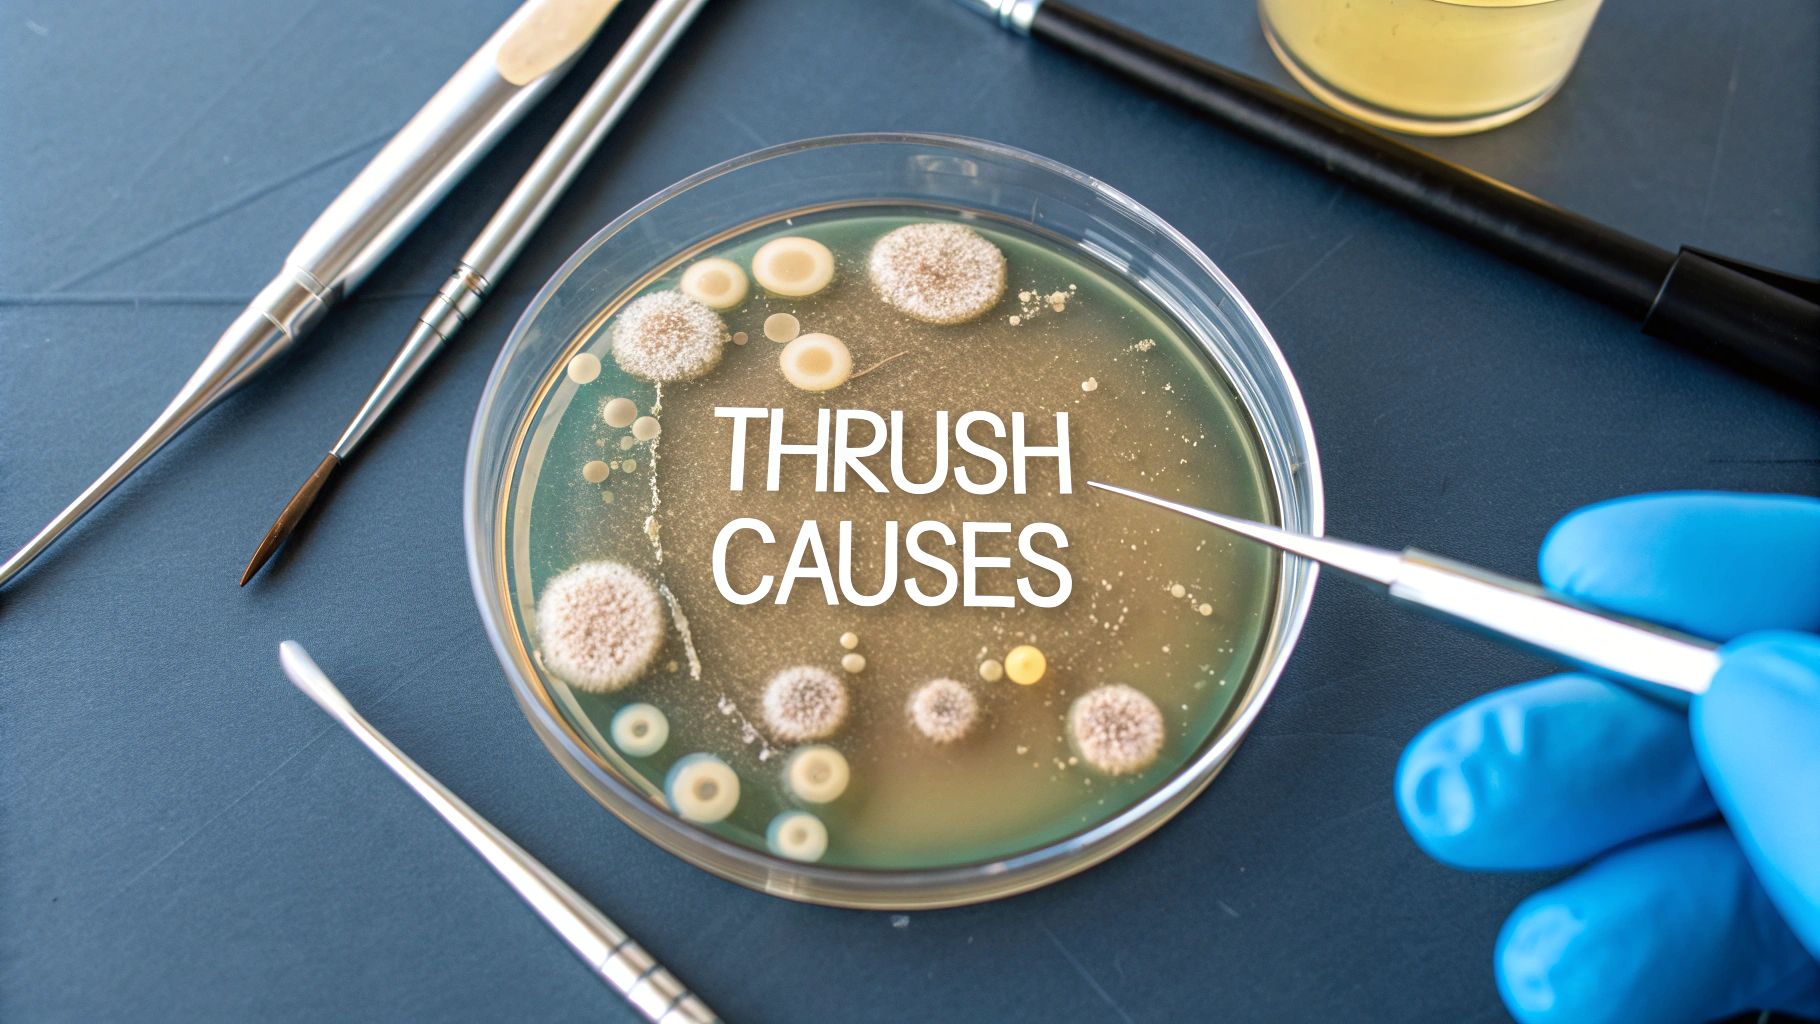
What Causes Thrush? Key Factors & How to Prevent It

At its core, thrush is caused by an overgrowth of a yeast that already lives on and in our bodies, called Candida. A good way to think about it is to picture your body's natural ecosystem, or microbiome, as a carefully balanced garden. In this garden, helpful bacteria work to keep opportunistic organisms like Candida from getting out of hand.
Thrush happens when something disrupts that delicate balance, giving the yeast a chance to multiply uncontrollably.

The root cause of thrush isn't some external bug you've caught—it's an imbalance from within. Candida albicans is a normal, harmless resident in our mouths, digestive systems, and genital areas, living quietly alongside countless other microbes.
The trouble starts when the local conditions change in its favour. It’s like a single type of weed in the garden suddenly getting the perfect mix of rain and sun to take over, choking out all the other plants. This is what leads to the classic symptoms of thrush, whether it’s the white patches of oral thrush or the familiar irritation of a genital infection.
So, what throws your body's natural harmony out of sync? Several things can tip the scales, making the environment much more welcoming for Candida to thrive. The main culprits usually fall into one of three camps:
The most important thing to remember is that thrush is really a symptom of an underlying disruption. Pinpointing what tipped the scales is the first step towards not just treating the infection, but preventing it from coming back.
When it comes to persistent issues like vaginal thrush, getting specialised care can make all the difference in diagnosing and managing these disruptions. You can learn more about the expert gynaecology services that address these kinds of concerns.
To make it even clearer, here’s a quick summary of the main factors that can lead to a thrush infection.
This table breaks down the common triggers that upset the microbial balance, allowing Candida to overgrow.
Understanding these triggers is the key to managing thrush effectively. By identifying what might be contributing to the imbalance in your own body, you can take proactive steps to restore harmony and keep infections at bay.

To really get what causes thrush, we first need to meet the culprit: a yeast called Candida albicans. But here’s the twist – it isn't some nasty invader from the outside. It's actually a natural, and usually harmless, resident of your body’s microscopic world, living quietly in your mouth, gut, and genital tract.
Think of your body's microbial community as a perfectly balanced ecosystem, like a well-tended garden. In this garden, trillions of different microorganisms—from helpful bacteria to yeasts like Candida—all have their own role. When everything is in harmony, they keep each other in check, preventing any single one from taking over.
The problem starts when something throws that delicate balance off-kilter. Imagine the 'good bacteria' that normally keep Candida in its place are suddenly wiped out, or your immune system gets distracted. This is Candida’s golden opportunity to grow unchecked and spread.
This overgrowth is what we call a thrush infection. It’s not a new germ you’ve caught, but a sign that your body's internal environment has changed, allowing a native resident to run wild.
So, what causes this disruption? The most common culprits are things that upset your body’s normal state:
Understanding this dual nature of Candida—as both a peaceful resident and a potential opportunist—is key. In cases of oral thrush, for instance, this overgrowth can lead to annoying symptoms like a metallic taste or a burning feeling. For more stubborn or persistent issues, treatments like an oral lesion excision might even be needed to get things back on track.
So, what gives Candida the green light to take over? While this yeast is a normal resident in our bodies, certain triggers can knock our internal ecosystem out of balance, creating the perfect conditions for it to grow out of control. Getting to grips with these triggers is the first step in stopping thrush before it even starts.
One of the most common culprits is a course of antibiotics. These drugs are lifesavers for bacterial infections, but they don't distinguish between good and bad bacteria. Think of them like a wildfire clearing a forest – they wipe out everything, leaving a void that opportunistic fungi like Candida can quickly colonise without any competition.
Hormonal changes are another major factor. The natural fluctuations that come with pregnancy, the menstrual cycle, or even taking contraceptive pills can alter the pH and glycogen (sugar) levels in the vagina. This shift creates a much more welcoming environment for yeast to flourish, which is why many women notice thrush appearing at certain times of the month or during pregnancy.
A weakened immune system also plays a huge part. When your body's defences are down—whether from stress, illness, or an underlying medical condition—it struggles to keep the Candida population in check. It’s like a security guard being taken off duty, allowing the yeast to multiply freely.
This infographic breaks down some of the main causes of thrush.

As you can see, things like antibiotic use, a weakened immune system, and hormonal shifts are all distinct yet powerful triggers for a Candida overgrowth.
Uncontrolled diabetes is another significant risk factor. Why? Because high blood sugar levels provide a feast for yeast. The excess sugar in saliva, urine, and vaginal secretions is a direct food source, helping Candida to multiply rapidly. For anyone with this condition, managing blood sugar is a critical part of preventing thrush. You can explore more about the connection between diabetes and overall health in our detailed guide.
Let's break down how these common triggers work in a bit more detail.
Each of these factors disrupts the delicate balance that keeps Candida in its place.
The key takeaway is that thrush is often a reaction to an internal change. Whether it's medication, hormones, or blood sugar, these triggers upset the delicate balance that normally keeps yeast under control.
This is more than just a minor inconvenience; it's a notable public health concern in the UK. In a recent year, England recorded 3.9 cases of yeast bloodstream infections per 100,000 people. Evidence also suggests these infection rates are higher in more deprived populations, highlighting how wider socioeconomic factors can influence a person’s susceptibility.
By identifying your personal triggers, you can take targeted steps to restore your body’s natural balance and keep thrush at bay.
It’s not just medical conditions that open the door to thrush. The choices you make every day can either help keep your body’s delicate ecosystem in check or accidentally create the perfect conditions for Candida to flourish.
Think of it like this: your diet can either be your best defence or the enemy’s best friend. A menu high in sugar and refined carbohydrates is basically a feast for yeast. Candida loves sugar, so giving it an endless supply encourages it to grow out of control, throwing your natural microbial balance completely off-kilter.
Even something as simple as what you wear can play a surprising part. Tight-fitting clothes made from synthetic fabrics like nylon or polyester are notorious for trapping heat and moisture. This creates the warm, damp environment where yeast thrives. A simple switch to breathable, natural fabrics like cotton—especially for underwear—can make a huge difference.
In the same way, some of the products we use can cause more harm than good. Harsh, perfumed soaps, bubble baths, and vaginal deodorants can easily irritate delicate skin. More importantly, they can disrupt the natural pH balance that acts as your body’s first line of defence against yeast overgrowth.
Adopting a holistic approach to wellness is key. Understanding how your habits affect your body, including the vital role and benefits of probiotics for gut health, is essential for maintaining balance and preventing thrush.
This isn’t just a minor inconvenience. Recent data shows that bloodstream infections from Candida species have seen a 42% increase in England since 2013. The infection rate now sits at 4.0 cases per 100,000 people, highlighting just how common these issues are becoming.
Finally, never underestimate the power of stress. Being in a state of chronic stress weakens your immune system, making it far less effective at keeping Candida under control. Learning some practical strategies for managing stress isn't just good for your mind; it's a powerful tool for keeping your body in balance, too.
Thrush doesn't pop up in the same way for everyone because, put simply, our bodies and circumstances are all unique. You can think of the Candida yeast like a picky plant—it only flourishes when the local environment is just right. Those "just right" conditions vary massively between different ages and genders.
For instance, oral thrush is a classic issue for babies. Their immune systems are still getting up to speed and aren't quite strong enough to keep the yeast that naturally lives in their mouths in check. At the other end of the spectrum, older adults can also be more susceptible, especially if they wear dentures or have a dry mouth, which creates a more inviting home for Candida.
When it comes to women, however, the conversation often turns to vaginal thrush.
Hormonal shifts are the biggest driver here. The natural fluctuations that happen during a menstrual cycle, pregnancy, or menopause can alter the pH balance and glycogen levels in the vagina, rolling out the red carpet for yeast to overgrow.
It’s an incredibly common problem, affecting up to 75% of women at some point in their reproductive years. For a significant minority, it becomes a frustrating, recurring issue. This has been made more complicated by a rise in antifungal resistance, which may have been partly influenced by a shift in primary care policy that encouraged treatment without lab tests.
For women navigating the major hormonal changes of perimenopause and menopause, understanding what’s happening in your body is the first step to managing it. You can learn more in our dedicated guide to menopause and perimenopause.
Men aren't immune to genital thrush, although it is less common. It usually appears as balanitis—an inflammation of the head of the penis—which causes uncomfortable redness, itching, and soreness.
Often, it’s passed on from a female partner during sex. But other risk factors, like poor hygiene, a weakened immune system, or unmanaged diabetes, can also be the trigger.
The key takeaway is that vulnerability to thrush is not random. It is closely linked to specific biological and life-stage factors—from the developing immunity of an infant to the hormonal cycles of a woman.

While it’s often tempting to head straight to the pharmacy for thrush, many cases are straightforward enough to be managed with over-the-counter treatments. However, some situations really do need a doctor's eye. Self-diagnosing isn’t foolproof, and knowing the red flags is key to staying on top of your health.
If this is your first time experiencing symptoms, that’s an immediate reason to book an appointment. A proper diagnosis from a GP confirms it’s definitely thrush and not something else with similar signs, like bacterial vaginosis or a sexually transmitted infection (STI), which need entirely different treatments.
You should also get medical advice if you find yourself dealing with recurrent infections. If thrush keeps coming back—four or more times in a year—it’s considered recurrent and could point to an underlying cause that needs a proper investigation.
It's also vital to see a GP if over-the-counter treatments aren't working or if your symptoms are particularly severe. Persistent discomfort or symptoms that are getting worse suggest you might need a stronger, prescription-based treatment to clear the infection for good.
Certain circumstances always warrant a professional consultation. Think of these as non-negotiable times to see a doctor:
Ultimately, consulting a healthcare professional is about getting the right diagnosis and a safe, effective treatment plan tailored to you. It takes the guesswork out of it and ensures you get better, faster.
When it comes to thrush, a few common questions always seem to pop up. Let's clear the air and give you some straightforward answers to help you understand what’s really going on.
This is a really common concern. While thrush isn't officially classed as a sexually transmitted infection (STI), the Candida yeast responsible for it can be passed between partners during sex.
It’s actually more common for men to get thrush from a female partner than the other way around. If you or your partner keep getting thrush, it can create a cycle of reinfection. The best approach is for both of you to get checked and, if necessary, treated at the same time to break the cycle.
For most people, a one-off case of thrush is just an annoying imbalance, not a red flag for a major health issue. However, if it keeps coming back, that’s when it might be your body’s way of signalling something else is going on.
Recurrent or persistent thrush can sometimes be a sign of uncontrolled diabetes, as high blood sugar levels create the perfect environment for yeast to thrive. It can also be linked to a weakened immune system. If you’re stuck in a frustrating loop of thrush infections, it's really important to see your GP to rule out any underlying causes.
Absolutely. There's a definite link between high stress levels and your risk of developing thrush. When you’re under chronic stress, your body produces more of the hormone cortisol, which can suppress your immune system.
A weakened immune system has a harder time keeping the naturally present Candida yeast in check. This gives it an opportunity to overgrow and cause a full-blown infection. This is why managing stress through things like exercise, mindfulness, or just getting enough sleep can be a surprisingly effective part of keeping thrush at bay.
At The Vesey Private Hospital, our specialists can provide a clear diagnosis and an effective treatment plan for persistent or complex cases of thrush. Visit our website to book a consultation and get the expert care you need.